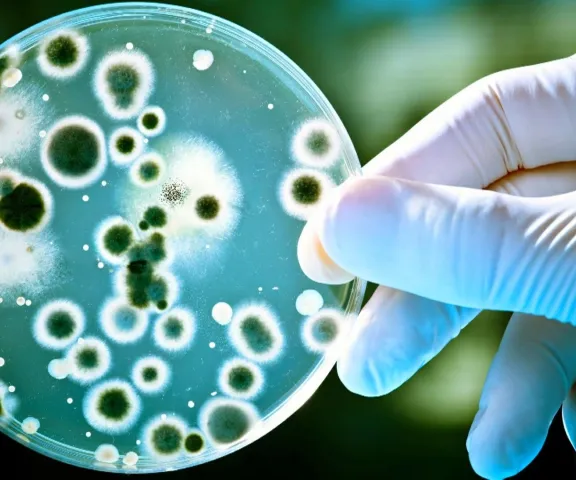

Город добрых
Неделя борьбы с антимикробной резистентностью
Просмотров: 46
С 18 по 24 ноября 2024 года в Новосибирской области объявлена неделя борьбы с антимикробной резистентностью. Неделя проводится по инициативе Регионального центра общественного здоровья и медицинской профилактики Министерства здравоохранения Новосибирской области.
Приглашаем общественные организации присоединиться к мероприятиям недели здоровья и провести мероприятие для своей аудитории. Полезные материалы для проведения мероприятия можно посмотреть на странице Регионального центра - https://rcmp-nso.ru/profila/info/antimicrob_week.php

